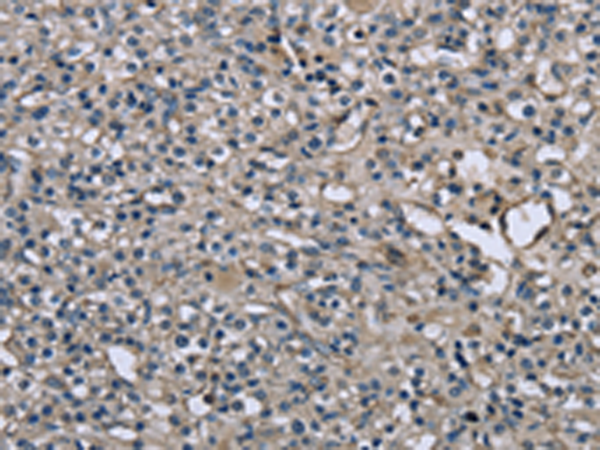
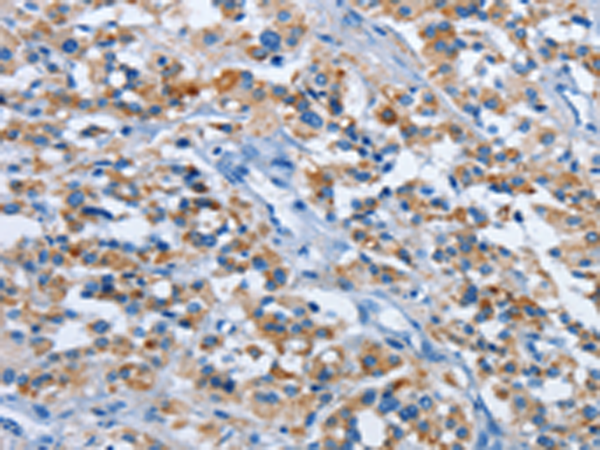
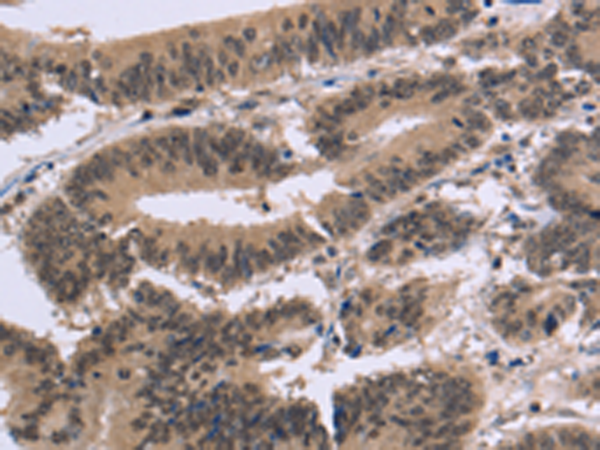
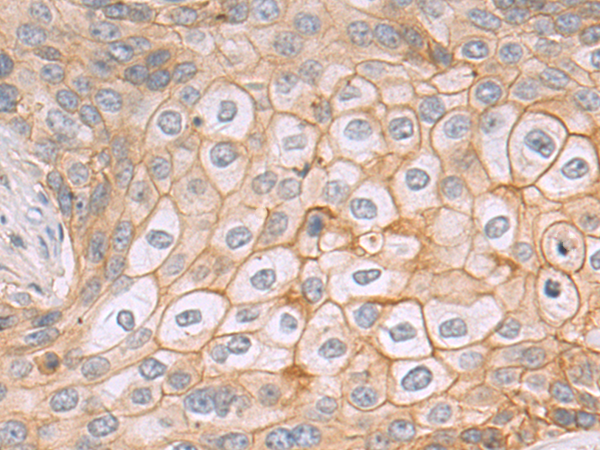
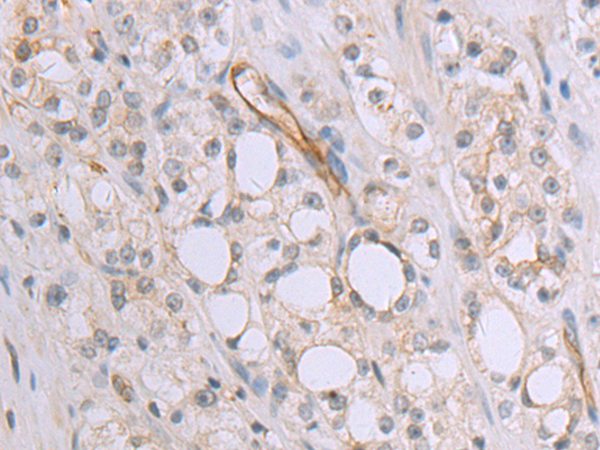

-
分类: 科研抗体货号: P08315别名: MLC-B; MRLC2应用: WB,IHC反应种属: Human, Mouse, Rat
-
分类: 科研抗体货号: P08296别名: HSCO; YF13H12应用: WB,IHC反应种属: Human, Mouse
-
分类: 科研抗体货号: P08308别名: DRR1; TU3A应用: IHC反应种属: Human
-
分类: 科研抗体货号: P08314别名: MLSTD1; SDR10E2应用: WB,IHC反应种属: Human, Mouse
-
分类: 科研抗体货号: P08294别名: ET1; PPET1; HDLCQ7应用: IHC反应种属: Human
-
分类: 科研抗体货号: P08307别名: PKB; PTK; CAKB; FAK2; PYK2; CADTK; FADK2; RAFTK应用: WB,IHC反应种属: Human, Mouse, Rat
-
分类: 科研抗体货号: P08313别名: FAPA; SIMP; DPPIV; FAPalpha应用: WB,IHC反应种属: Human, Mouse
-
分类: 科研抗体货号: P08292别名: endocan应用: IHC反应种属: Human
-
分类: 科研抗体货号: P08306别名: LFG; LFG2; NGP35; NMP35; TMBIM2应用: WB,IHC反应种属: Human, Mouse, Rat
-
分类: 科研抗体货号: P08311别名: FAF应用: IHC反应种属: Human

鄂公网安备42018502007531号
鄂公网安备42018502007531号

